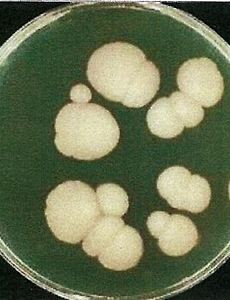

세균 결막염 (bacterial conjunctivitis)의 일반적인 임상양상 및 분류
세균 결막염 (bacterial conjunctivitis)는... 문자그대로.. 세균에 의해서 결막염이 발생하는 것으로... 정상적으로 존재하는 결막의 방어기전을 이겨내고,세균이 증식하여, 결막 상피층을 통과하여결막에서 염증 반응을 일으킴을 의미합니다. 세균 결막염 (bacterial conjunctivitis)의 임상양상 1. 결막의 충혈과 부종 2. 삼출액 (눈곱) 삼출액의 구성은... 염증세포(PMN : Polymorphonuclear cells), 탈락한 상피세포, 세균, 단백질, 섬유소, 점액, 장액 으로 되어 있습니다. 초기에는 결막 분비물이 많지 않고, 삼출성으로 흰눈꼽(mucus strand)이 끼다가 점점 결막의 술잔세포(goblet cell)의 분비가 증가하고, 염증세포가 증가하게되면..
2017. 12. 15.
세균 결막염 (bacterial conjunctivitis)의 일반적인 임상양상 및 분류
세균 결막염 (bacterial conjunctivitis)는... 문자그대로.. 세균에 의해서 결막염이 발생하는 것으로... 정상적으로 존재하는 결막의 방어기전을 이겨내고,세균이 증식하여, 결막 상피층을 통과하여결막에서 염증 반응을 일으킴을 의미합니다. 세균 결막염 (bacterial conjunctivitis)의 임상양상 1. 결막의 충혈과 부종 2. 삼출액 (눈곱) 삼출액의 구성은... 염증세포(PMN : Polymorphonuclear cells), 탈락한 상피세포, 세균, 단백질, 섬유소, 점액, 장액 으로 되어 있습니다. 초기에는 결막 분비물이 많지 않고, 삼출성으로 흰눈꼽(mucus strand)이 끼다가 점점 결막의 술잔세포(goblet cell)의 분비가 증가하고, 염증세포가 증가하게되면..
2017. 12. 15.
세균 결막염 (bacterial conjunctivitis)의 발병원인, 발병기전, 원인균
눈은... 출생당시부터 산도를 통과하면서 질내 정상세균들에 노출되고, 이후 성장함에 따라서 주위환경으로 부터 오염 또는 손이나 안검의 피부 등에 있는 세균등에 의해 끊임 없이 노출됨으로써, 결막낭의 정상균주 및 잠정적인 균주가 형성되게 됩니다. 즉, 정상적으로 결막의 표면에는 각종 세균들이 살고 있는데.. 이를 정상상재균(normal flora)라고 합니다. 이때 이러한 정상상재균 보다 독성이 강한, 증식력이 강한 세균들이 눈에 들어오게 되면... 정상상재균을 죽이거나, 억제하고 이들보다 더 많은 증식을 하게 됩니다. 독성이 강한 세균들이 눈에서 증식하게되면 염증이 발생하는데, 이를 "외인성 세균성 결막염"이라고합니다. 외인성 결막염의 원인은... 손을 통한 감염, 성병 분비물을 통한 감염, 오염된 안약..
2017. 12. 14.
세균 결막염 (bacterial conjunctivitis)의 발병원인, 발병기전, 원인균
눈은... 출생당시부터 산도를 통과하면서 질내 정상세균들에 노출되고, 이후 성장함에 따라서 주위환경으로 부터 오염 또는 손이나 안검의 피부 등에 있는 세균등에 의해 끊임 없이 노출됨으로써, 결막낭의 정상균주 및 잠정적인 균주가 형성되게 됩니다. 즉, 정상적으로 결막의 표면에는 각종 세균들이 살고 있는데.. 이를 정상상재균(normal flora)라고 합니다. 이때 이러한 정상상재균 보다 독성이 강한, 증식력이 강한 세균들이 눈에 들어오게 되면... 정상상재균을 죽이거나, 억제하고 이들보다 더 많은 증식을 하게 됩니다. 독성이 강한 세균들이 눈에서 증식하게되면 염증이 발생하는데, 이를 "외인성 세균성 결막염"이라고합니다. 외인성 결막염의 원인은... 손을 통한 감염, 성병 분비물을 통한 감염, 오염된 안약..
2017. 12. 14.